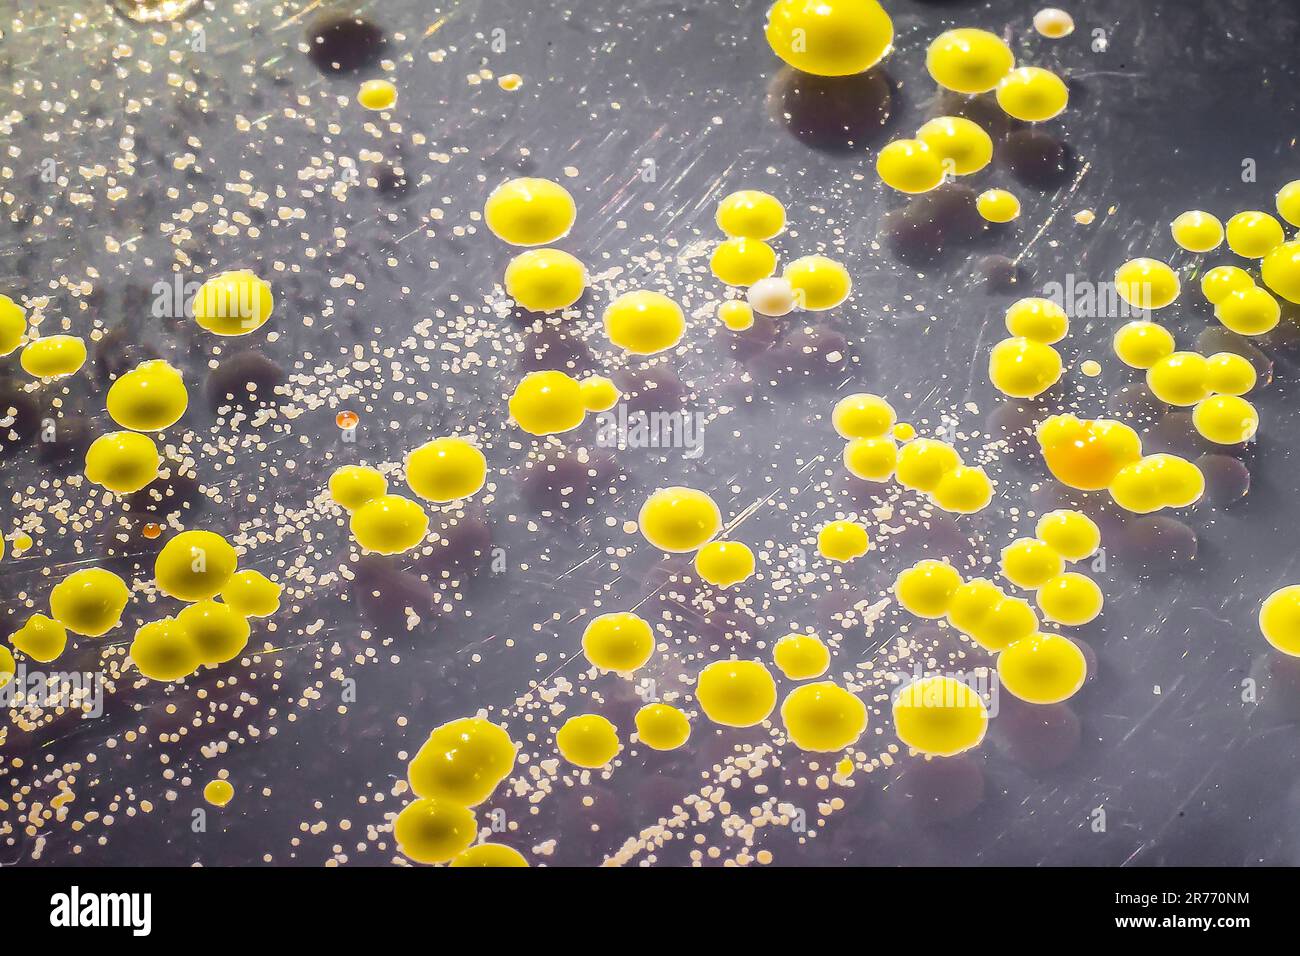
Bactéries cultivées à partir d'un frottis cutané, colonies de Micrococcus luteus et de Staphylococcus epidermidis sur gélose trypticase soja. Banque D'Images

Bactéries cultivées à partir d'un frottis cutané, colonies de Micrococcus luteus et de Staphylococcus epidermidis sur gélose trypticase soja.
RFID:ID de l’image:2R770NM
Détails de l'image
Contributeur:
Dr_MicrobeID de l’image:
2R770NMTaille du fichier:
151,9 MB (6,5 MB Téléchargement compressé)Autorisations:
Modèle - non | Propriété - nonUne autorisation est-elle nécessaire?Dimensions:
8924 x 5950 px | 75,6 x 50,4 cm | 29,7 x 19,8 inches | 300dpi